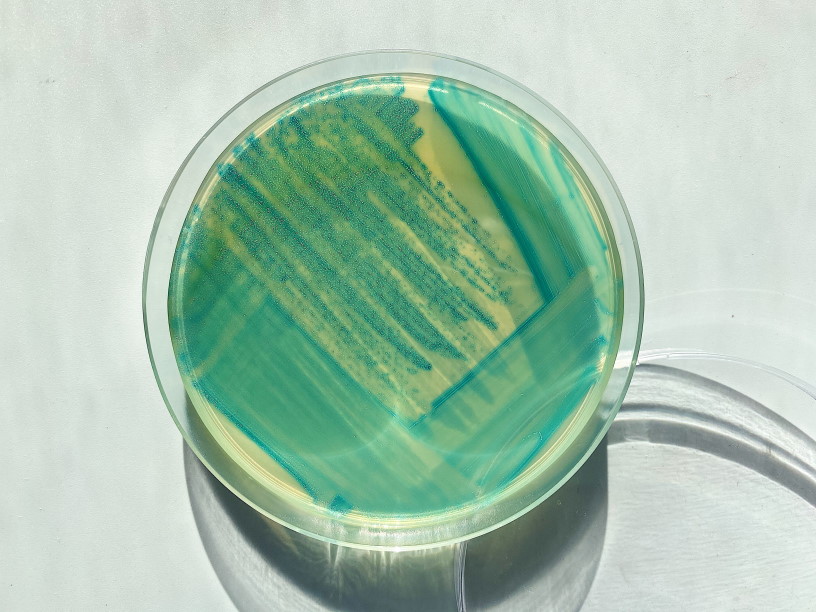

Промикробы: Аристократическая бледность
Бледная трепонема (Treponema pallidum) — вид грамотрицательных спирохет, T. pallidum, подвид pallidum является возбудителем сифилиса. Открыта в 1905 году немецкими микробиологами Фрицем Шаудином и Эрихом Гофманом.
⠀
По Граму она не окрашивается, обладает просто модельной внешностью — длинная и тонкая, с завитками, количеством от 8 до 14. Бледная трепонема способна к винтообразным, сгибательным и контрактильным движениям, обеспечиваемым фибриллами и собственными сокращениями клетки трепонемы. Тело бледной трепонемы окружено слизевидной капсулой, выполняющей защитную функцию. Ввиду наличия большого числа гидрофобных компонентов в цитоплазме трепонема плохо прокрашивается анилиновыми красителями, но окрашивается в бледно-розовый цвет по методу Романовского–Гимзе (за что, собственно, и получила название «бледная трепонема»). Неокрашенные нефиксированные живые трепонемы не видны в световой микроскоп, для их визуализации применяют метод темнопольной микроскопии, фазово-контрастные микроскопы или метод флюоресцентных антител.
⠀
Вырастить трепонему в чашке Петри — очень трудная задачка, так как ее предпочтения весьма специфичны. Она хемоорганогетеротроф, облигатный анаэроб, и на простых питательных средах расти отказывается. Конечно, ученые не сдавались и напридумывали кучу мудреных методов культивирования, для которых требуется то лошадиная сыворотка, то асцитическая жидкость, то тестикулы кролика. Всё это больше похоже на ведьмино снадобье или зелье из саги о Гарри Поттере, я согласна. Особенно страдают кролики, потому что они восприимчивы к бледной спирохете и являются удобным организмом для моделирования сифилиса.
⠀
Бледная трепонема обладает уникальной биологической особенностью: её размножение может происходить только в очень узком интервале температур — около 37 °C. На этом явлении основан метод пиротерапии сифилиса. Бактерия размножается делением один раз в 30–32 часа. При 40–42 °C вне человеческого организма трепонема погибает в течение 3–6 часов. При 55 °C — за 15 минут. Бледная трепонема устойчива к низким температурам. В замороженном состоянии при –18 °C она в течение одного года не теряет жизнеспособность. Трепонемы быстро погибают при высушивании. Они очень чувствительны к воздействию химических веществ. 50–60-процентный этиловый спирт вызывает немедленную потерю подвижности, а кислоты и щелочи быстро убивают трепонему. Кроме того, она быстро гибнет в пищевых продуктах, содержащих кислоты. Не знаю, насколько полезна эта информация, но в крайнем случае можно квасом, уксусом или колой рот прополоскать. Это, конечно, шутка, никаких советов по самолечению и самодиагностике я вам не даю.
⠀
Про возбудителя поговорили, пора переходить к самой болезни, но тут я в тупике. Во-первых, мне кажется, что про сифилис вы и без меня много знаете, а во-вторых, про него можно рассказывать слишком много и долго. Поэтому давайте по основным вершкам пробежимся. Сифилис — инфекционное заболевание, вызываемое бледной трепонемой, передаваемое преимущественно половым путем, характеризующееся поражением кожи, слизистых оболочек, нервной системы, внутренних органов и опорно-двигательной системы, а также плода. В классическом течении сифилиса различают 4 периода, последовательно сменяющих друг друга: инкубационный (скрытый), первичный, вторичный и третичный. Единственным источником заражения сифилисом является больной человек, так как в естественных условиях только он болеет данной инфекцией. Такое вот бремя человека.